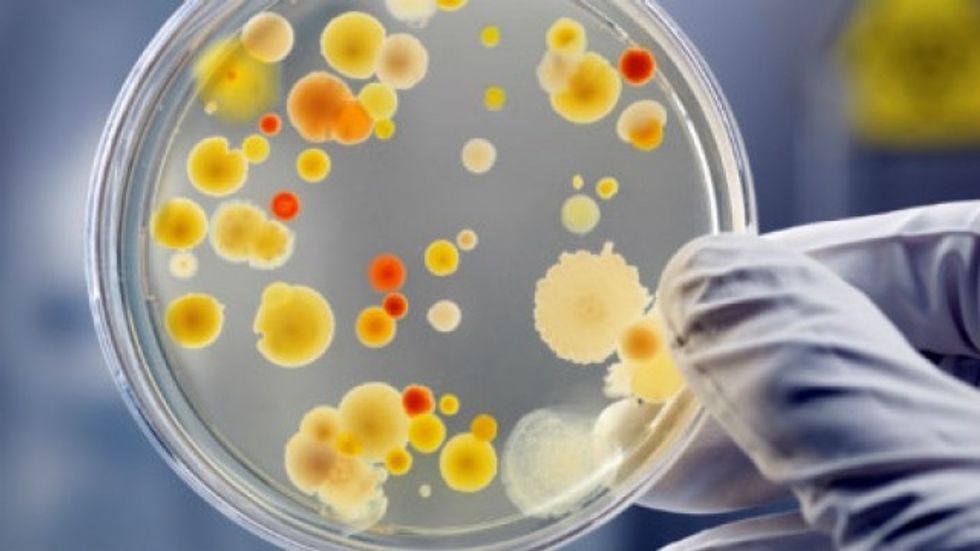
imunotoksina 3b3 pe38 mund t rsquo i shkat euml rroj euml qelizat e infektuara me hiv hd

Shërohet një tjetër pacient me HIV, shkencëtarët tregojnë si e bëri këtë

Është fakt i njohur se për momentin nuk ka ilaç që e shëron HIV-in dhe pavarësisht faktit se i prek 36.9 milionë njerëz në botë, epidemia e këtij virusi vazhdon të shpërndahet qysh prej kur është shfaqur fillimisht në vitet e 1980’ta.
Edhe pse ka disa ilaçe antiretrovirale të cilat mund të ndihmojnë në trajtimin e virusit, ai nuk arrin të shërohet krejtësisht, transmeton Telegrafi.
Megjithatë, shkencëtarët kanë menaxhuar të bëjnë diçka të jashtëzakonshme për herë të dytë duke arritur ta shërojnë nga HIV-i një të rritur në Londër.
Hera e parë kur ka ndodhur kjo ka qenë në vitin 2007 kur një mashkull nga Belgjika, Timothy Ray Brown, ishte shëruar nga HIV-i. Kjo kishte ndodhur kur ishte diagnostikuar me leukemi akute dhe i ishte nënshtruar kimioterapisë, rrezatimit dhe transplantimit të qelizave amë.
Këtu tani bëhet interesant. Donatori i qelizave amë i cili përshtatej me Thomas Brown gjithashtu kishte pasur CCR5, i cili është mutacion gjenetik që e kishte bërë atë imun nga virusi i HIV-it.
Pasi Thomas-i i ishte nënshtruar kirurgjisë për transplantimin e qelizave amë dhe i kishte ndaluar të gjitha ilaçet që i përdorte, testimet kishin treguar se virusi i HIV-it ishte zhdukur dhe ai ishte shëruar.

Sidoqoftë, pas shumë testeve, doktorët nuk kishin mundur t’i përsëritnin rezultatet dhe pasi kishin dështuar shumë herë, ata kishin ndaluar së provuar.
Kjo për shkak se ata kishin zbuluar se transplantimi i qelizave amë është procedurë e rrezikshme dhe e vështirë.
Profesori Ravindra Gupta dhe ekipi i tij nga Universiteti i Londrës nuk ishin pajtuar me procedurën e qelizave amë dhe kishin shpjeguar në letrën e tyre se jo vetëm që është shumë e rrezikshme, por është edhe shumë e shtrenjtë për të provuar të shërohen të gjithë njerëzit me HIV.
Prandaj, ata kishin vendosur të hulumtonin dhe zhvillonin diçka tjetër.
Këtu ka filluar magjia! Rreth një dekadë më vonë, një pacient tjetër nga Londra, emri i të cilit ende nuk dihet, bëhet personi i dytë që është shëruar nga HIV-i dhe kjo u ka rritur shpresat njerëzve tjerë në botë që janë të sëmurë nga ky virus.
Pacienti ishte sëmurë me HIV në vitin 2003 dhe pastaj ishte diagnostikuar edhe me një formë të rrallë të kancerit në sistemin limfatik në vitin 2012.
Në vitin 2016, pacienti ishte sëmurë shumë dhe doktorët kishin gjetur një donator për transplantim të qelizave amë i cili po ashtu kishte mutacionin gjenetik CCR5, i cili e bënte atë imun nga virusi HIV.
Ndërhyrja kirurgjike kishte shkuar mirë, por më vonë kishte pasur efekte anësore. Pasi që qelizat e imunitetit të donatorit kishin filluar t’i sulmonin qelizat e imunitetit të pacientit, pacienti kishte pasur vështirësi për një periudhë të shkurtë kohore.
Në fund, rezultatet kishin treguar se virusi i HIV-it ishte zhdukur dhe më në fund ai ka qenë i aftë t’i ndalte ilaçet antiretrovirale.
Pas kësaj, doktorët e kanë shpallë atë në Londër si njeriu i dytë që shërohet nga HIV-i.
Dr. Ravindra Gupta ka thënë se tani janë në rrugën e duhur për të zbuluar se çfarë metode mund ta përdorin për ta shëruar HIV-in. /Telegrafi/